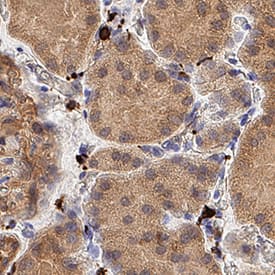

Human CD163 Antibody
R&D Systems, part of Bio-Techne | Catalog # AF1607


Key Product Details
Species Reactivity
Validated:
Cited:
Applications
Validated:
Cited:
Label
Antibody Source
Product Specifications
Immunogen
Gly41-Ser1045
Accession # CAA80543
Specificity
Clonality
Host
Isotype
Scientific Data Images for Human CD163 Antibody
Detection of Human CD163 by Western Blot.
Western blot shows lysates of human thymus tissue, human liver tissue, and human placenta tissue. PVDF membrane was probed with 1 µg/mL of Goat Anti-Human CD163 Antigen Affinity-purified Polyclonal Antibody (Catalog # AF1607) followed by HRP-conjugated Anti-Goat IgG Secondary Antibody (HAF019). A specific band was detected for CD163 at approximately 150 kDa (as indicated). This experiment was conducted under reducing conditions and using Immunoblot Buffer Group 1.Detection of Human CD163 by Simple WesternTM.
Simple Western lane view shows lysates of human placenta tissue, loaded at 0.2 mg/mL. A specific band was detected for CD163 at approximately 179 kDa (as indicated) using 10 µg/mL of Goat Anti-Human CD163 Antigen Affinity-purified Polyclonal Antibody (Catalog # AF1607) followed by 1:50 dilution of HRP-conjugated Anti-Goat IgG Secondary Antibody (HAF109). This experiment was conducted under reducing conditions and using the 12-230 kDa separation system.Detection of CD163 in Human Kidney.
CD163 was detected in immersion fixed paraffin-embedded sections of Human Kidney using Goat Anti-Human CD163 Antigen Affinity-purified Polyclonal Antibody (Catalog # AF1607) at 5 µg/mL for 1 hour at room temperature followed by incubation with the Anti-Goat IgG VisUCyte™ HRP Polymer Antibody (Catalog # VC004). Before incubation with the primary antibody, tissue was subjected to heat-induced epitope retrieval using VisUCyte Antigen Retrieval Reagent-Basic (Catalog # VCTS021). Tissue was stained using DAB (brown) and counterstained with hematoxylin (blue). Specific staining was localized to fibroblasts. View our protocol for IHC Staining with VisUCyte HRP Polymer Detection Reagents.Applications for Human CD163 Antibody
Immunohistochemistry
Sample: Immersion fixed paraffin-embedded sections of Human Kidney
Simple Western
Sample: Human placenta tissue
Western Blot
Sample: Human thymus tissue, human liver tissue, and human placenta tissue
Reviewed Applications
Read 2 reviews rated 5 using AF1607 in the following applications:
Formulation, Preparation, and Storage
Purification
Reconstitution
Formulation
Shipping
Stability & Storage
- 12 months from date of receipt, -20 to -70 °C as supplied.
- 1 month, 2 to 8 °C under sterile conditions after reconstitution.
- 6 months, -20 to -70 °C under sterile conditions after reconstitution.
Background: CD163
CD163, previously called M130 or p155, is a 130-160 kDa type I transmembrane glycoprotein that belongs to group B of the cysteine-rich scavenger receptor family (1-3). It is essential for clearance of hemoglobin-haptoglobin (Hb-Hp) complexes in the liver, spleen and circulation (4). The human CD163 contains a 41 amino acid (aa) signal sequence, a 1009 aa extracellular domain (ECD) with 9 scavenger receptor cysteine-rich (SRCR) domains, a 22 aa transmembrane segment, and a
39‑84 aa cytoplasmic region (1). The third SRCR domain is crucial for calcium-dependent binding of hemoglobin/haptoglobin complexes (3). Three splice forms (isoforms 2, 3 and 4) vary within their intracellular regions (1, 5), while one isoform (# 4) also has a 34 aa insert between SRCR domains 5 and 6 within the ECD. While all are expressed, isoform 3 is the most abundant, being generally expressed on the cell surface and most active in endocytosis (5). An approximately 130 kDa soluble form of human CD163 (sCD163) is assumed to contain virtually all of the ECD, which shares 74%, 75%, 84%, 86%, 86%, and 87% aa identity with mouse, rat, bovine, equine, porcine and canine CD163 ECD, respectively (6, 7). It is released from the cell surface by proteolysis after oxidative stress or inflammatory stimuli, including bacterial endotoxins and activation of the Toll-like receptors TLR2 or TLR5 (7 - 10). Expression of CD163 is constitutive, and induced by glucocorticoids, IL-10, IL-6 or endotoxin on circulating monocytes, tissue macrophages, and at low levels on monocyte-derived dendritic cells (1, 2, 11, 12). In addition to clearing Hb-Hp complexes, CD163 is also a scavenger receptor for free Hb (if Hp is depleted) and TWEAK (TNF-like weak inducer of apoptosis), and can function as an erythroblast adhesion receptor (4, 13-15).
References
- Law, S.K.A. et al. (1993) Eur. J. Immunol. 23:2320.
- Sulahian, T.H. et al. (2000) Cytokine 12:1312.
- Madsen, M. et al. (2004) J. Biol. Chem. 279:51561.
- Kristiansen, M. et al. (2001) Nature 409:198.
- Nielsen, M.J. et al. (2006) J. Leukoc. Biol. 79:837.
- Moller, H.J. et al. (2002) Blood 99:378.
- Droste, A. et al. (1999) Biochem. Biophys. Res. Commun. 256:110.
- Hintz, K. A. et al. (2002) J. Leukoc. Biol. 72:711.
- Weaver, L.K. et al. (2006) J. Leukoc. Biol. 80:26.
- Timmerman, M. and P. Hogger (2005) Free Radic. Biol. Med. 39:98.
- Buechler, C. et al. (2000) J. Leukoc. Biol. 67:97.
- Pulford, K.A. et al. (1989) J. Clin. Pathol. 42:414.
- Schaer, D.J. et al. (2006) Blood 107:373.
- Bover, L.C. et al. (2007) J. Immunol. 178:8183.
- Fabriek, B.O. et al. (2007) Blood 109:5223.
Alternate Names
Gene Symbol
UniProt
Additional CD163 Products
Product Documents for Human CD163 Antibody
Product Specific Notices for Human CD163 Antibody
For research use only